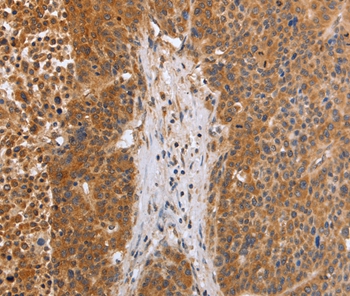

EGLN3 Antibody (OAEB02283)
OAEB02283
ApplicationsWestern Blot
Product group Antibodies
TargetEGLN3
Overview
- SupplierAviva Systems Biology
- Product NameEGLN3 Antibody (OAEB02283)
- Delivery Days Customer23
- ApplicationsWestern Blot
- CertificationResearch Use Only
- ClonalityPolyclonal
- FormatSupplied at 0.5 mg/ml in Tris saline, 0.02% sodium azide, pH7.3 with 0.5% bovine serum albumin.
- Gene ID112399
- Target nameEGLN3
- Target descriptionegl-9 family hypoxia inducible factor 3
- Target synonymsHIFP4H3; HIFPH3; HIF-PH3; HIF-prolyl hydroxylase 3; HPH-1; HPH-3; hypoxia-inducible factor prolyl hydroxylase 3; PHD3; prolyl hydroxylase domain-containing protein 3; prolyl hydroxylase EGLN3
- HostGoat
- Storage Instruction-20°C
- UNSPSC12352203